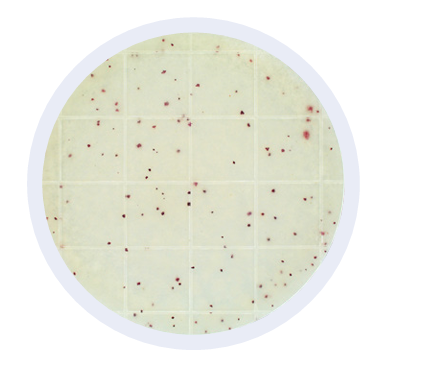
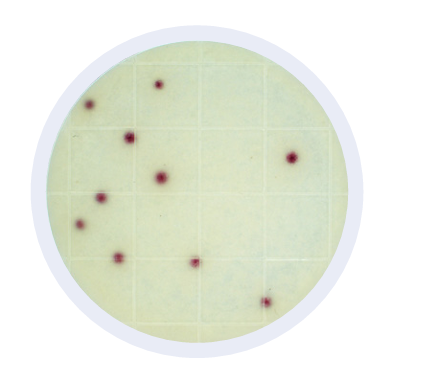
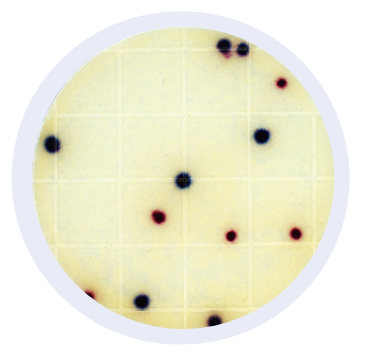
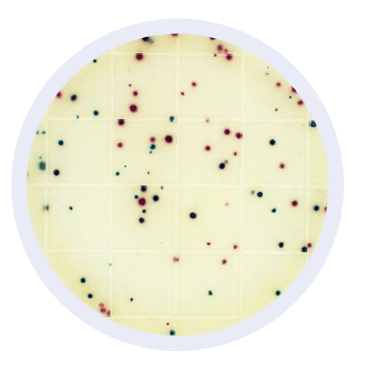
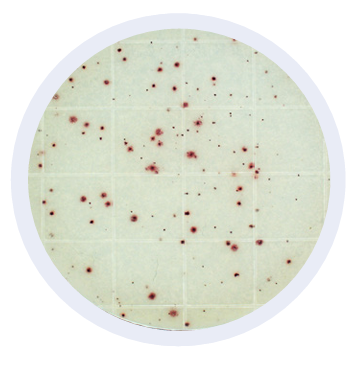
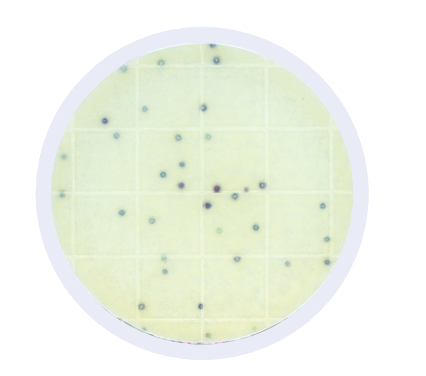

Peel Plate Microbial Tests
Microbiological Testing Reinvented
Peel Plate Microbial Tests are simplified alternatives to conventional microbiological testing. They are designed for sanitation verification, product shelf life monitoring, and as early warnings of pathogen risks.
Results can be documented, recorded, and proactively mitigated in your effective food safety and consumer protection programs.
Validated food matrices include dairy products, meat, produce rinses, water, and the buffers used in environmental food production area monitoring. With Peel Plate tests, you receive the same trusted conventional microbiological results without the media prep time and labor. In addition, Peel Plate tests use easy to interpret color development to determine bacterial growth. Please refer to specific test interpretation guides for more information on counting colonies.
Each single-use microbial test contains prepared media in a shallow dish with an adhesive top cover. To plate a food or water sample simply peel up the adhesive to expose the media, pipette into the center of the plate, and watch the sample wick and spread into the media. The test gels solidify within 10 seconds (30 seconds for High Volume tests). Plates are designed for uniform incubation and air flow and have an air space above growth to allow opening and picking of colonies for additional microbiological procedures and identification.
Benefits
1. Ready-to-use media – self-wicking, no spreader device required
2. 12-month room temperature stability when stored in a re-sealable foil zip bag*
3. Buffered media formulation for robust performance with acidic foods and neutralizing buffers – pH adjustments not required for most samples
4. Convenient plate stacking and built-in air space design for improved air circulation and picking colonies
5. Date tracking and count analysis available with the use of the Peel Plate Colony Counter
*High Volume tests and certified milk labs require refrigerated storage (0 – 4.5°C)
Procedure

peel Plate AC Test
Peel Plate CC Test
Total Coliform Peel Plate CC selective media encourages the growth of coliform bacteria. The presence of coliform is an indicator of unsanitary conditions in raw products. Coliform are killed by effective heat steps in food processing. Coliform appear as red colonies within 24 hours at 32 or 35°C. Coliforms are closely regulated in dairy and some foods the US and Peel Plate Coliform tests are listed in the PMO.
Peel Plate EB Test
The Enterobacteriaceae bacteria are a family of gram negative bacteria encompassing coliform, E. coli, Shigella, Salmonella, and Yersinia. These bacteria indicate unsanitary conditions in raw products and are killed by heat steps in food processing. EB testing is used as a post-production verification of process and pathogen risk used, for example, to test dry milk powder and infant formula. EB is regulated globally, similar to coliform/E.coli regulation in the US. Incubation 24 to 48 hours at 37°C produce multiple colored round growth spots that are all recorded as EB. High Volume plates are available. Visit the Peel Plate EB test page to learn more.
Peel Plate EC Test
Generic E.coli, considered a fecal risk indicator, is a subset of coliform and are differentiated with the Peel Plate EC formulation. Peel Plate EC are AOAC-RI validated for a number of dairy products, meat rinses, water testing, and environmental sampling. Coliform appear as round red colonies and E. coli as round blue colonies within 24 hours at 35°C and the sum of red and blue are total coliform.
Peel Plate HET Test
Heterotrophs are aerobic bacteria that are more associated with water and nutrient-depleted matrices. Peel Plate HET nutrient-depleted media encourages the growth of heterotrophic organisms in water. Incubation at 20 to 28°C produces red growth spots within 5 to 7 days. Heterotrophs are used as indicators to assess biofilm build-up, and nutrient leaching in water distribution systems of food plants and water municipalities.
Peel Plate SA Test
Staphylococcus aureus can be present in eggs, meat, poultry, milk, and dairy products and are spread through hand contact with environmental surfaces or hand-prepared food items. Peel Plate SA tests are used to test finished products and environmental samples. S. aureus bacteria appear within 24 hours, with an additional 24 hours for presumptive positive confirmation (48 hours total) at 35 to 37°C. Tests with no growth at 24 hours are considered negative for S. aureus.
Peel Plate Y Test

Peel Plate Y uses alternative indicators from the YM test to select for yeast colony growth only. It recommends 32°C incubation that is more favorable to yeast growth compared to mold. The method is particularly for use in foods naturally containing molds, i.e., blue cheese. It uses media containing selective agents and dyes to produce dehydrogenase enzymes, which react with a redox indicator to produce red or pink colored colonies.
Peel Plate YM Test

Peel Plate selective media with antibiotic prevents the growth of bacteria, and encourages the growth of fungi. Fungi organisms are primarily a food spoilage risk but can also produce toxins. Peel Plate YM are AOAC-RI validated for a variety of dairy products, fresh fruits and vegetables, juices, RTE foods, and environmental surfaces. Incubation 3 to 5 days at 25ºC produce green/blue growth spots. High Volume plates are available.